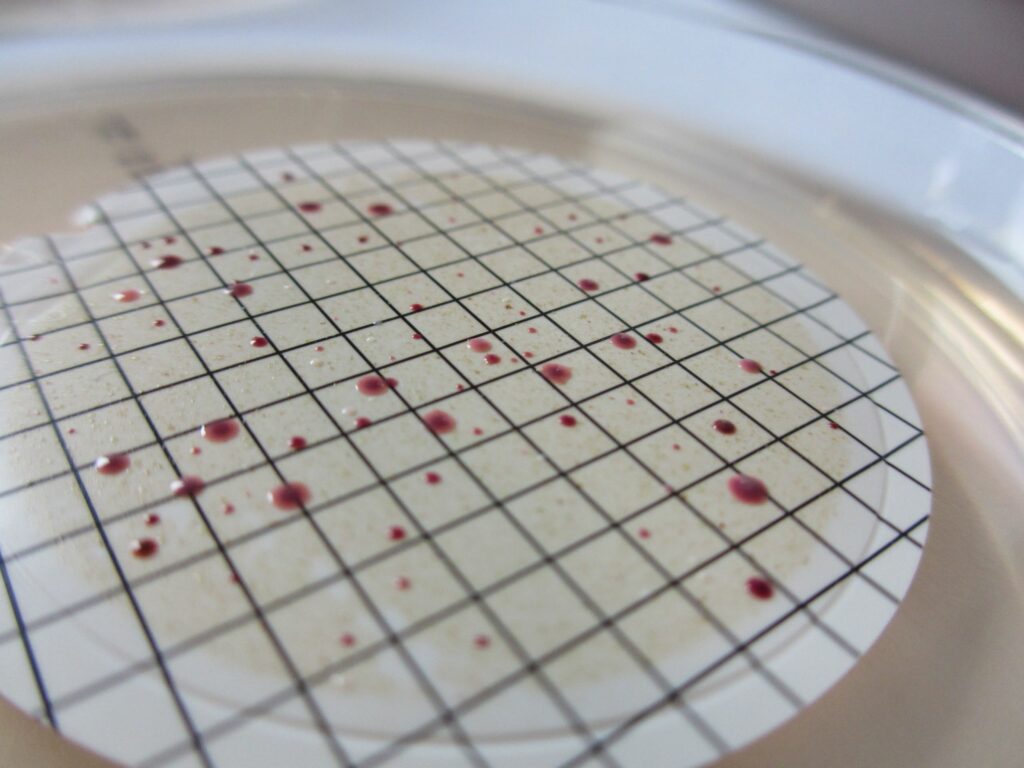

Sie sind Trinkwasserversorger? Die Überwachung von Roh- und Trinkwasser soll zuverlässig und schnell erfolgen? Sie müssen dem Gesundheitsamt Analysen Ihres Hausbrunnens vorlegen oder möchten wissen, wie Ihr Wasser beschaffen ist? Sie sind Hauseigentümer bzw. Hausverwalter und für die Absicherung der Überwachung der Legionellen in der Warmwasserversorgung zuständig? Als Baubetrieb oder Installateur benötigen Sie zeitnah Hygienefreigaben nach Abschluss der Bauarbeiten?
Probenahme und Analytik müssen bei Untersuchungen nach Trinkwasserverordnung (TrinkwV) „aus einer Hand“ – durch ein dafür akkreditiertes Labor erfolgen. Im Bereich der Probenahme sind wir regional tätig und für Kunden im Raum Sachsen sowie südliches Brandenburg und Sachsen-Anhalt unterwegs.
Wir untersuchen auf alle Parameter, die nach der aktuellen Trinkwasserverordnung gefordert werden, außer auf radioaktive Stoffe (das erfolgt in einem Partnerlabor). Zu unserem Portfolio gehören vor-Ort-Parameter (z. B. pH-Wert, Leitfähigkeit, Chlor), mikrobiologische Parameter (z. B. Koloniezahlen, Coliforme Keime, E. coli, Enterokokken, Clostridien, Pseudomonas aeruginosa, Legionellen), chemisch-physikalische Parameter (z. B. Pflanzenschutzmittel / Pestizide, Chlorid, Nitrit, Eisen, Blei, Cadmium. Calcium und Magnesium, Calcitlösekapazität) und sensorische Parameter (z. B. Geruchsschwellenwert).
Wir bieten Ihnen spezielle Untersuchungsprogramme für Hausbrunnen an. Darin sind sowohl mikrobiologische Parameter als auch z. B. Eisen, Mangan, Nitrat und pH-Wert enthalten.
Als Tierhalter möchten Sie wissen, was Ihre Tiere trinken? Häufig wird zum Tränken Wasser aus eigenen Brunnen verwendet. Die Qualität und hygienische Beschaffenheit von Tränkwasser für Ihre Tiere kann deren Gesundheitszustand beeinflussen. Hier gelten keine Grenzwerte wie bei der TrinkwV, aber ein Abgleich mit Richtwerten ist möglich. Wir helfen Ihnen gern dabei, den Bedarf zu ermitteln.

Ansprechpartnerin


